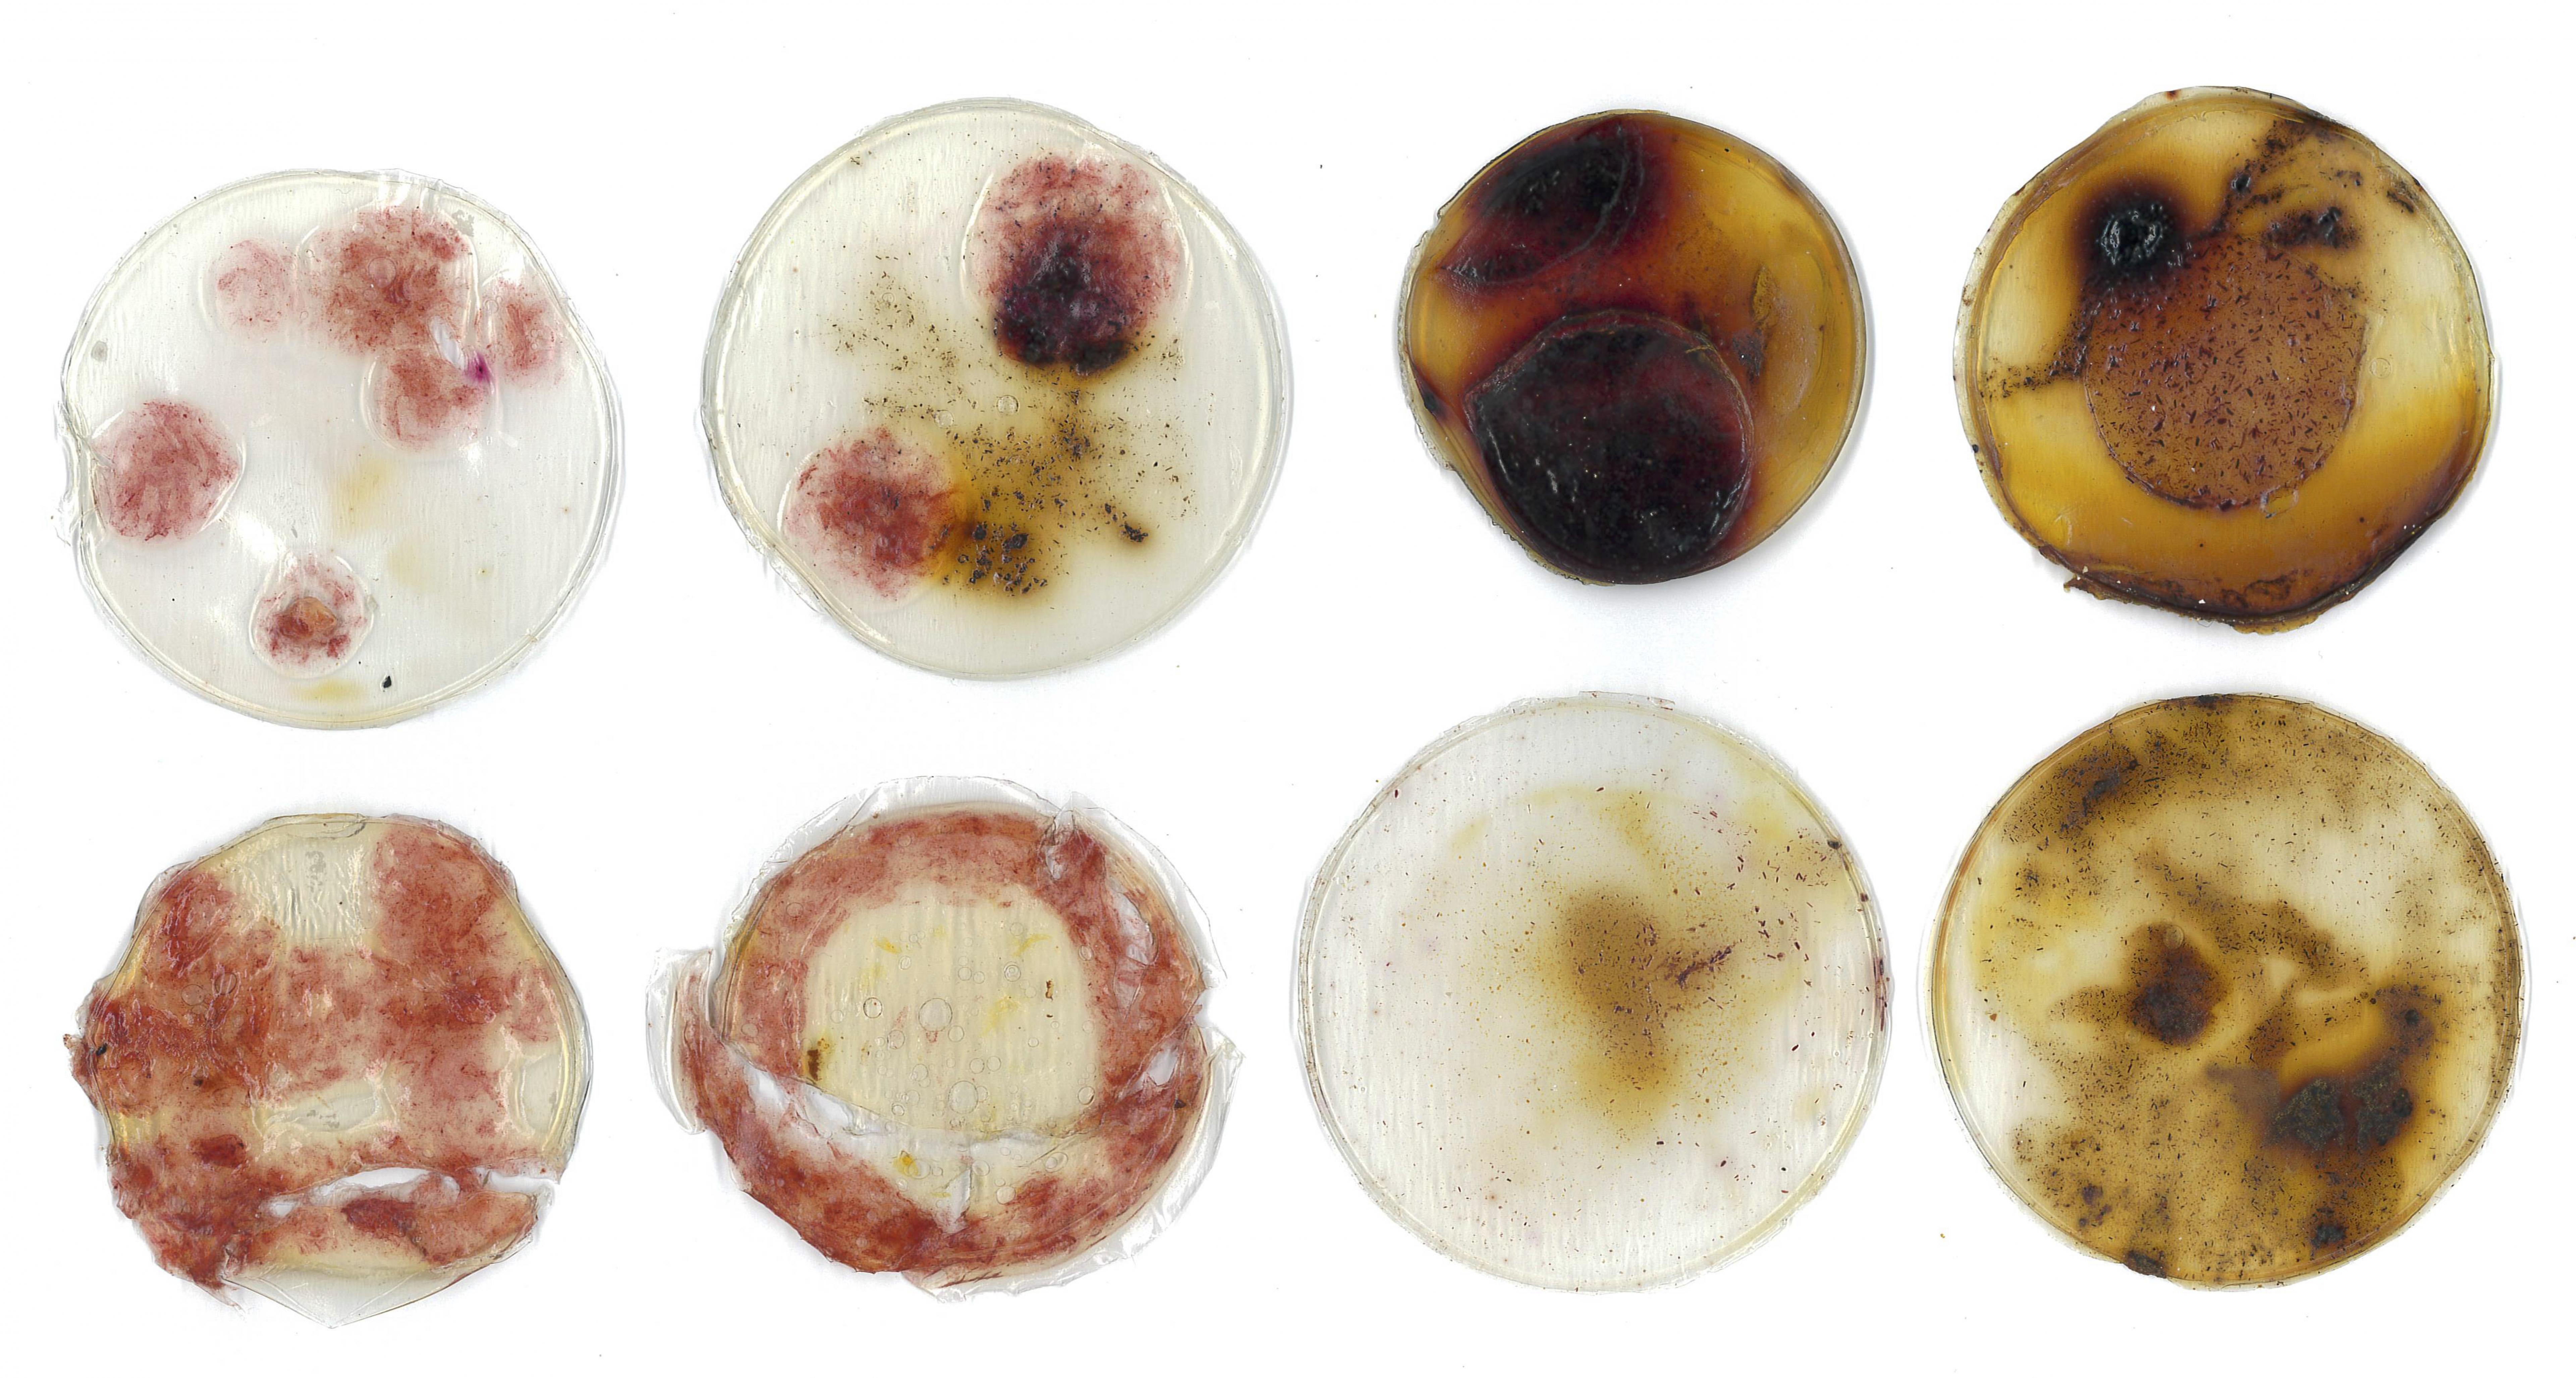
Anchisa Kaewjoey | Fashion & Textiles 1

Bâan Bâan explores the connection between urban Thai culture and natural ecosystems through textile art. Inspired by mycelium communication networks and city social patterns, the work reflects on sustainability, harmony, and life’s cyclic nature.
Using natural fibres, biomaterials, and traditional Thai Ikat weaving techniques, these works envision a future where humans and nature live in harmony.